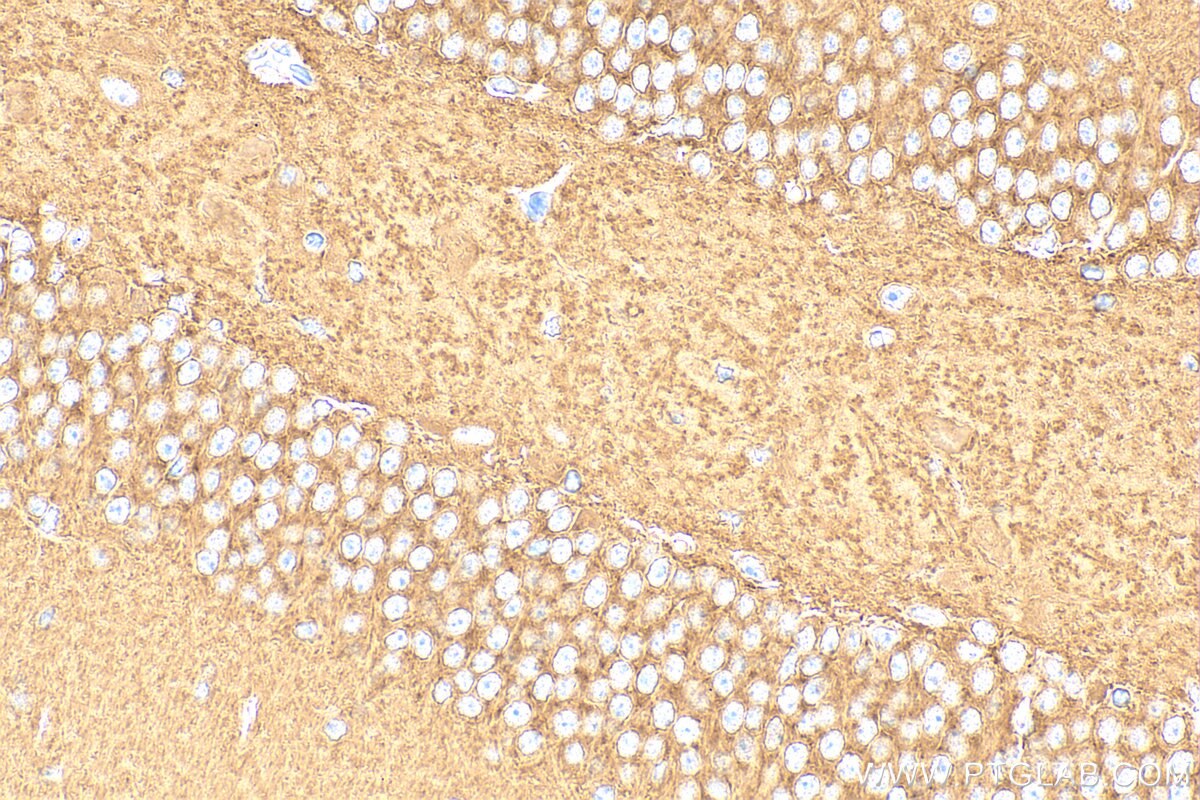
Immunohistochemistry (IHC) staining of mouse brain tissue using ATP6V1B2 Polyclonal antibody (15097-1-AP)

Tested Applications
| Positive WB detected in | HepG2 cells, A549 cells, HeLa cells, mouse brain tissue, mouse heart tissue, mouse skeletal muscle tissue, K-562 cells, L02 cells, rat brain tissue |
| Positive IP detected in | mouse brain tissue |
| Positive IHC detected in | human colon cancer tissue, mouse brain tissue Note: suggested antigen retrieval with TE buffer pH 9.0; (*) Alternatively, antigen retrieval may be performed with citrate buffer pH 6.0 |
Recommended dilution
| Application | Dilution |
|---|---|
| Western Blot (WB) | WB : 1:2000-1:10000 |
| Immunoprecipitation (IP) | IP : 0.5-4.0 ug for 1.0-3.0 mg of total protein lysate |
| Immunohistochemistry (IHC) | IHC : 1:200-1:800 |
| It is recommended that this reagent should be titrated in each testing system to obtain optimal results. | |
| Sample-dependent, Check data in validation data gallery. | |
Published Applications
| WB | See 16 publications below |
| IHC | See 1 publications below |
| IP | See 2 publications below |
Product Information
15097-1-AP targets ATP6V1B2 in WB, IHC, IP, ELISA applications and shows reactivity with human, mouse, rat samples.
| Tested Reactivity | human, mouse, rat |
| Cited Reactivity | human, mouse, pig, monkey |
| Host / Isotype | Rabbit / IgG |
| Class | Polyclonal |
| Type | Antibody |
| Immunogen |
CatNo: Ag7174 Product name: Recombinant human ATP6V1B2 protein Source: e coli.-derived, PGEX-4T Tag: GST Domain: 162-511 aa of BC003100 Sequence: CRIYPEEMIQTGISAIDGMNSIARGQKIPIFSAAGLPHNEIAAQICRQAGLVKKSKDVVDYSEENFAIVFAAMGVNMETARFFKSDFEENGSMDNVCLFLNLANDPTIERIITPRLALTTAEFLAYQCEKHVLVILTDMSSYAEALREVSAAREEVPGRRGFPGYMYTDLATIYERAGRVEGRNGSITQIPILTMPNDDITHPIPDLTGYITEGQIYVDRQLHNRQIYPPINVLPSLSRLMKSAIGEGMTRKDHADVSNQLYACYAIGKDVQAMKAVVGEEALTSDDLLYLEFLQKFERNFIAQGPYENRTVFETLDIGWQLLRIFPKEMLKRIPQSTLSEFYPRDSAKH Predict reactive species |
| Full Name | ATPase, H+ transporting, lysosomal 56/58kDa, V1 subunit B2 |
| Calculated Molecular Weight | 57 kDa |
| Observed Molecular Weight | 56-58 kDa |
| GenBank Accession Number | BC003100 |
| Gene Symbol | ATP6V1B2 |
| Gene ID (NCBI) | 526 |
| RRID | AB_2243297 |
| Conjugate | Unconjugated |
| Form | Liquid |
| Purification Method | Antigen affinity purification |
| UNIPROT ID | P21281 |
| Storage Buffer | PBS with 0.02% sodium azide and 50% glycerol, pH 7.3. |
| Storage Conditions | Store at -20°C. Stable for one year after shipment. Aliquoting is unnecessary for -20oC storage. 20ul sizes contain 0.1% BSA. |
Background Information
ATP6V1B2(V-type proton ATPase subunit B, brain isoform) is also named as ATP6B2, VPP3,HO57. It belongs to the ATPase alpha/beta chains family.V-ATPase is an heteromultimeric enzyme composed of a peripheral catalytic V1 complex attached to an integral membrane V0 proton pore complex.The quasi-ubiquitous ATP6V1B2 is one of 2 isoforms of ATP6V1 and is expressed in most cell types, where it plays a major role in organelle acidification(PMID:18667600).
Protocols
| Product Specific Protocols | |
|---|---|
| IHC protocol for ATP6V1B2 antibody 15097-1-AP | Download protocol |
| IP protocol for ATP6V1B2 antibody 15097-1-AP | Download protocol |
| WB protocol for ATP6V1B2 antibody 15097-1-AP | Download protocol |
| Standard Protocols | |
|---|---|
| Click here to view our Standard Protocols |
Publications
| Species | Application | Title |
|---|---|---|
Nat Microbiol The interferon-inducible isoform of NCOA7 inhibits endosome-mediated viral entry. | ||
Autophagy KAT7-mediated CANX (calnexin) crotonylation regulates leucine-stimulated MTORC1 activity. | ||
Cell Mol Life Sci The Ncoa7 locus regulates V-ATPase formation and function, neurodevelopment and behaviour. | ||
Microorganisms Exopolysaccharides from Bifidobacterium animalis Ameliorate Escherichia coli-Induced IPEC-J2 Cell Damage via Inhibiting Apoptosis and Restoring Autophagy. | ||
J Cancer Upregulation of V-ATPase by STAT3 Activation Promotes Anoikis Resistance and Tumor Metastasis. | ||
Vet Res Butyrate-mediated autophagy inhibition limits cytosolic Salmonella Infantis replication in the colon of pigs treated with a mixture of Lactobacillus and Bacillus. |